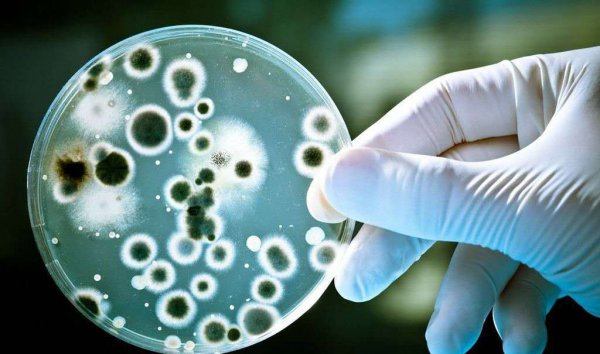
阴干的衣服好臭怎么办

阴干的衣服好臭怎么办 为什么洗完的衣服晾干后发臭(2)

阴雨天气洗衣服了,空气也是潮湿的,当人们收衣服的时候,手的触感形成了错觉,导致以为衣服是干的,其实此时的衣服并没有完全干透。
这时候就把衣服放进衣柜里,几天过后想把衣服拿出来穿,结果发现衣服是臭的,其实这也是因为滋生了细菌。
空气里悬浮细菌的芽孢,这些芽孢通过衣服被带进衣柜里,在衣柜潮湿和较温暖的环境下,非常有利于细菌的繁殖,衣服同样是被细菌的代谢产物所污染,就变臭了。
解决办法:在阴雨天气收衣服的情况下,可以使用吹风筒进一步将衣物吹干,待衣服变得更干后再放入衣柜中就能防止变臭了。
如果还不放心,可以在衣柜内增添一些干燥剂或者除湿盒,以保证衣服处在一个干燥的环境中。

细菌的滋生也需要一定的条件和时间,当然家里有烘干机把衣服及时烘干是最好的了。
但是,如果家里的衣服真的因为没晾干而变臭了,希望以上的两个方法能帮助到大家。
以上常识社介绍的为什么洗完的衣服晾干后发臭 以及 阴干的衣服好臭怎么办的具体介绍,供网友们借鉴参考。
相关阅读
-
为什么82年的拉菲最贵 为什么都说82年的拉菲最好
常识社网小编为你介绍为什么都说82年的拉菲最好和为什么82年的拉菲最贵的相关知识,接下来常识社网小编就来介绍。 受商品竞争、收藏价值等因素的影响,正宗拉菲的价格每年都会波动。
-
家长送给老师最实用的礼物 这几种礼物不费钱老师也不为难
正文核心导读:这几种礼物不费钱老师也不为难和家长送给老师最实用的礼物的小经验,接下来小编为您详细解答 教师节给老师送这几种礼物,既不费钱,老师也不为难,还特显心意! 教师是
-
早上好立冬文案短句 立冬的文案句子
今天介绍早上好立冬文案短句方面的介绍,一起来了解了解吧。 立冬到,问个好,愿你心情好,快乐幸福没烦恼,愿你精神好,舒心顺心更开心,愿你身体好,平安如意身体健,愿你生活好,
-
品牌水杯十大名牌排名 实用好看的十大品牌杯子推荐
如果想了解品牌水杯十大名牌排名方面的内容,接下来常识社小编为大家介绍。 将会介绍到的杯子品牌: Drink in the Box Monbento水杯 NUOC水杯 韩国乐扣乐扣 Kinto日本家居品牌 Joseph Joseph THERMOS膳魔


